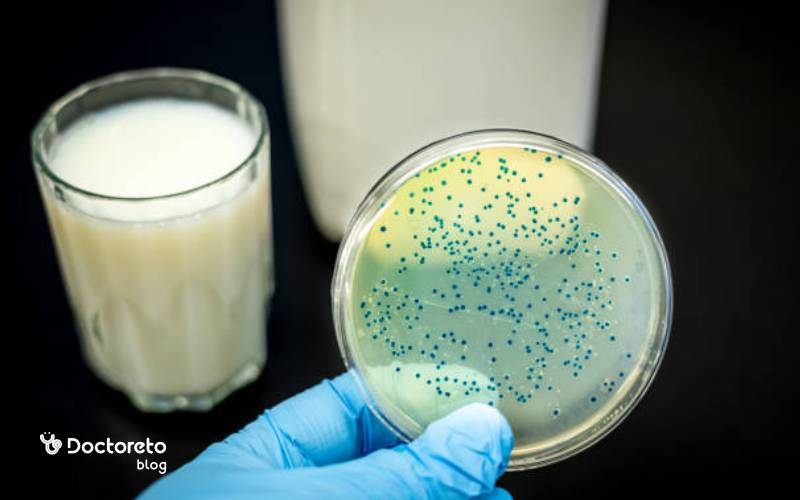
عامل تب مالت چیست؟

فهرست مطالب
خلاصه این مطلب را در این پادکست گوش دهید:
تب مالت یا بروسلوز یکی از بیماریهای عفونی قابلانتقال از حیوان به انسان است که بیشتر از طریق مصرف لبنیات غیرپاستوریزه، گوشت نیمپز یا تماس مستقیم با دام آلوده منتقل میشود. این بیماری در بسیاری از مناطق دامپرور کشور همچنان شایع است و بهدلیل بروز تبهای طولانی، تعریق شبانه و دردهای عضلانی و مفصلی، میتواند کیفیت زندگی بیمار را برای مدت طولانی تحتتأثیر قرار دهد. در این مقاله از دکترتو، بررسی میکنیم که تب مالت دقیقاً چیست، چه علائمی دارد، چگونه تشخیص داده میشود و چه روشهایی برای درمان و پیشگیری از آن وجود دارد.
تب مالت چیست؟
بیماری تب مالت یا بروسلوز (Brucellosis)، نوعی بیماری عفونی است که توسط باکتری بروسلا ایجاد میشود. این باکتری از راه مصرف محصولات دامی آلوده، مانند شیر غیرپاستوریزه و گوشت آلوده به انسان منتقل میشود. علاوه بر انسان، برخی حیوانات از جمله گاو، بز، گوسفند و سگ نیز میتوانند به این عفونت مبتلا شوند. این بیماری را در حیوانات با نامهای مختلفی ازجمله تب مواج، تب دیوانه و تب مدیترانهای نیز میشناسند اما در انسانها بیشتر به تب مالت مرسوم است.
نشانههای بروسلوز معمولا تب، درد عضلانی و خستگی است و میتواند در همه فصول شیوع داشته باشد. عفونت با آنتی بیوتیک طی چند هفته تا چند ماه درمان میشود، البته ممکن است دوباره عود کند. بروسلوز، صدها هزار انسان و حیوان در سراسر دنیا را تحت تاثیر قرار میدهد. پرهیز از لبنیات خام و پاستوریزه نشده و رعایت اقدامات احتیاطی در تماس با حیوانات میتوانند از ابتلا به این بیماری پیشگیری کنند.
تب مالت واگیر دارد؟
انتقال تب مالت از انسان به انسان بسیار نادر است و معمولا راه انتقال تب مالت از دام یا محصولات دامی آلوده است. با این حال انتقال از مادر به جنین در بارداری، از طریق شیر مادر، رابطه جنسی و به ندرت خون آلوده گزارش شده است. راهّای پیشگیری اصلی از انتقال تب مالت مصرف فراوردههای لبنی پاستوریزه، رعایت بهداشت شغلی در دامداریها و آزمایش و واکسیناسیون دامها انجام میشود. اگر در محیطهای پرخطر کار میکنید استفاده از دستکش، ماسک و عینک محافظ ضروری است.
متن انگلیسی:
به نقل از my.clevelandclinic
Brucellosis isn’t considered a sexually transmitted infection (STI). There have only been rare cases of brucellosis spreading through sexual contact.
ترجمه متن فارسی:
بروسلوز (تب مالت) یک بیماری منتقله از راه جنسی (STI) محسوب نمیشود. تنها در موارد بسیار نادری گزارش شده است که بروسلوز از طریق رابطه جنسی منتقل شده باشد.
علائم تب مالت چیست؟
تب مالت معمولا به آرامی شروع میشود. علائم اولیه تب مالت شامل تب، لرز، عرق شبانه با بوی مشخص، خستگی، بیاشتهایی و دردهای پراکنده عضلانی و مفصلی همراه است. در برخی بیماران کبد و طحال بزرگ میشود و حساسیت مهرههای کمر یا مفاصل لگن دیده میشود. الگوی تب اغلب موجدار است یعنی چند روز بالا و بعد پایین میآید و دوباره برمیگردد. اگر درمان به تعویق بیفتد، بیماری مزمن میشود و با خستگی طولانی و دردهای ماندگار مفصلی و کمردرد تظاهر میکند. بهصورت کلی نشانه های تب مالت به شرح زیر است:
- تب همراه با لرز و عرق شبانه
- بدندرد و درد مفاصل به ویژه زانو، مچ و کمر
- خستگی
- بیاشتهایی و کاهش وزن
- بزرگی کبد و طحال
- درد شکم یا حساسیت پهلو
- در موارد پیچیده درگیری ستون فقرات، بیضه، کبد، اعصاب یا قلب
- بیحالی و خستگی
- سردرد
برخی نشانهها مدت طولانیتری باقی میمانند و برخی علائم هم هرگز برطرف نشده یا ممکن است دوباره برگردند مانند:
- تب متقاطع
- آرتروز
- تورم کیسه بیضه
- تورم قلب
- علائم عصبی
- خستگی مزمن
- افسردگی
- تورم کبد یا طحال

علائم تب مالت در بزرگسالان
علائم تب مالت بزرگسالان بستگی به شدت عفونت و وضعیت سلامت عمومی فرد دارد. در بعضی از موارد، عفونت بدون علائم خاصی ایجاد میشود ولی در موارد دیگر ممکن است با علائم شدیدتری همراه باشد. علائم تب مالت در زنان ممکن است اختلال قاعدگی یا درد لگن باشد و علائم تب مالت در مردان شامل التهاب بیضه در کنار سایر علائم است.
از علائم بروسلوز در بزرگسالان میتوان به تب دورهای، خستگی و ضعف، تعریق شبانه، سردرد، کاهش اشتها و علائمی مانند سرفه، تنگی نفس، درد در ناحیه شکم، تغییرات عصبی و اختلالات گوارشی اشاره کرد. . اگر درد قفسه سینه، تنگی نفس یا تپش قلب دارید باید از نظر درگیری قلبی بررسی شوید.
علائم تب مالت در کودکان چیست؟
کودکان معمولا با علائمی مثل تب طولانیمدت، بیحالی، درد اندامها و گاهی لنگیدن به پزشک مراجعه میکنند. درد مفاصل و استخوانها، تعریق شبانه و کاهش اشتها شایع است و ممکن است کبد و طحال بزرگ شود. در کودکان تشخیص سریع و انتخاب رژیم دارویی مناسب سن اهمیت زیادی دارد تا از عود و درگیری استخوانی جلوگیری شود. بهطورکلی علائم تب مالت به شرح زیر است:
- تب و تشنج در کودکان
- خستگی و ضعف و بیعلاقگی به فعالیتهای روزمره
- عرق شبانه
- سردرد
- کاهش اشتها
- درد عضلانی و مفصلی
- سرفه
علائم تب مالت استخوانی
بروسلوز استخوانی، شکل جدی و نادری از عفونت بروسلوز است که باعث آسیبدیدگی استخوانها و مفاصل میشود. از علائم تب مالت استخوانی میتوان به موارد زیر اشاره کرد:
- درد استخوانی بهصورت موضعی یا در سراسر بدن
- التهاب مفاصل، درد، تورم، سفتی و محدودیت حرکت در مفاصل
- تغییر شکل، ضعف استخوانی و حتی شکستگی استخوانها
- علائم عمومی شامل تب، خستگی، تعریق شبانه، کاهش وزن، افزایش ضربان قلب و احساس ناراحتی عمومی

علائم پوستی تب مالت
در تب مالت علائم پوستی شایع نیست، اما وقتی رخ میدهد میتواند سرنخ مهمی برای تشخیص باشد؛ بهویژه اگر همراه تب طولانی و علائم بدنی مثل خستگی، تعریق شبانه و درد مفاصل باشد. التهاب ناشی از بروسلا گاهی به پوست میرسد و الگوهای متفاوتی ایجاد میکند. از راشهای منتشر و گذرا تا ضایعات عمقیتر و دردناک. هر ضایعه پوستی در فردی با مواجهه غذایی یا شغلی پرخطر باید جدی گرفته شود، چون تأخیر در تشخیص میتواند به درگیری مفاصل یا ستون فقرات منجر شود.
عامل تب مالت چیست؟
تب مالت نوعی بیماری باکتریایی است که از گونههای مختلف بروسلا ایجاد شده که بیشتر گاو، بز، گوسفند، خوک و سگها را آلوده میکند. باکتریهای جنس بروسلا، میکروارگانیسمهایی هستند که داخل سلولهای بدن پنهان میشوند و با همین ویژگی درمان را دشوارتر میکنند. منابع اصلی آلودگی در انسان فراوردههای دامی غیرایمن مثل شیر و پنیر محلی غیرپاستوریزه، خامه و سرشیر، گوشت نیمپز یا تماس مستقیم با ترشحات زایمانی و مواد سقط جنین دام هستند. در محیطهای پرریسک مثل دامداری، کشتارگاه و آزمایشگاه، استنشاق ذرات آلوده نیز میةواند علت تب مالت باشد.
از کجا بفهمم تب مالت دارم؟
ترکیب نشانههای تب مالت و سابقه مواجهه با باکتر بروسلا، راه اصلی تشخیص این بیماری است. اگر تب موجدار بیش از چند روز، تعریق شبانه با بوی خاص، بیحالی، بدندرد و درد مفاصل دارید و در چند هفته گذشته لبنیات محلی مصرف کردهاید یا با دام سر و کار داشتهاید، باید احتمال ابتلا به بروسلوز در نظر گرفته شود.
درد عمقی کمر یا لگن که با حرکت بدتر میشود، بزرگی کبد و طحال یا حساسیت روی مهرهها احتمال درگیری استخوانی را بالا میبرد. در این موقعیت مراجعه سریع، درخواست آزمایشهای اختصاصی و شروع درمان بهموقع از مزمن شدن بیماری و عوارض بعدی جلوگیری میکند. تشخیص تب مالت معمولا از طریق آزمایشات پزشکی زیر صورت میگیرد:
- آزمایش خون: از جمله آزمایش سرولوژی، آزمایش واکنش زنجیرهای پلیمراز (PCR) و آزمایش هماگلوتیناسیون ساده (SAT)
- بررسی نمونه سرم خون برای شناسایی آنتیبادیها
- آزمایش مایع نخاعی جهت تشخیص عفونت مغز و نخاع
آزمایش تب مالت
روش اصلی تشخیص آزمایشگاهی، سرولوژی و کشت است. آزمایش تب مالت wright یا Standard Tube Agglutination تیتر آنتیبادیهای ضدبروسلا را اندازهگیری میکند. علامت اختصاری تب مالت در آزمایش خون عبارت Brucella است. کشت خون معیار طلایی است ولی زمانبر بوده و ممکن است بهدلیل بار میکروبی کم، جواب منفی کاذب بدهد. در مواردی از PCR برای تشخیص سریعتر استفاده میشود. تفسیر نتایج همیشه باید کنار علائم و نحوه تماس با باکتری انجام شود، نه صرفاً بر اساس عدد آزمایش.
| آزمایش تب مالت | کاربرد | نکته |
|---|---|---|
| آزمایش سرولوژی (Wright, SAT) | اندازهگیری آنتیبادیهای ضد بروسلا | تیتر بالا نشانه عفونت فعال است. |
| آزمایش PCR | تشخیص سریع DNA باکتری | در مراحل اولیه دقت بالایی دارد. |
| کشت خون | معیار طلایی تشخیص | زمانبر است و ممکن است منفی کاذب دهد. |
| آزمایش مایع نخاعی | بررسی درگیری سیستم عصبی | در بروسلوز عصبی انجام میشود. |
| بررسی واکنش پوستی | کمک تشخیصی | حساسیت پایینتر نسبت به سایر روشها دارد. |
خواندن جواب ازمایش تب مالت
تیتر بالاتر از حد در آزمایش تب مالت wright، همراه با جواب ازمایش تب مالت مثبت و علائم بالینی، معمولا بیانگر این است که عفونت فعال بوده و نیازمند درمان است. آزمایش تب مالت منفی، بیماری را کاملا رد نمیکند زیرا شروع زودهنگام آنتیبیوتیک، بودن در مرحله اولیه بیماری یا نقص ایمنی میتواند نتیجه را با خطا همراه کند. پس از درمان موفق، انتظار داریم عدد تب مالت در ازمایش بهتدریج کاهش یابد، اما ممکن است ماهها مثبت باقی بمانند و این بهتنهایی نشانه عود نیست. برای تفسیر جواب آزمایش تب مالت باید به متخصص عفونی مراجعه کنید.

چه چیزهایی برای درمان تب مالت خوب است؟
درمان قطعی تب مالت فقط با مصرف آنتیبیوتیک ترکیبی و کامل ممکن است، زیرا بروسلا داخلسلولی است و درمان تکدارویی یا کوتاه، زمینه عود و مقاومت را فراهم میکند. دوز داروهای استاندارد بزرگسالان شامل داکسیسایکلین بههمراه ریفامپینمعمولا برایشش هفته است. گاهی استرپتومایسین تزریقی نیز تجویز میشود. انتخاب دقیق روش درمان تب مالت به سن، بارداری، درگیریهای موضعی و تحمل دارویی بستگی دارد. در کنار دارو، استراحت نسبی، آب کافی، تغذیه سبک، کنترل تب و درد و پیگیری منظم، به درمان سريع تب مالت کمک میکند. بهطورکلی راههای درمان بروسلوز عبارتند از:
- دستهای از آنتیبیوتیکها مانند داروی داکسی سایکلین، ریفامپین و استرپتومایسین به عنوان درمان اولیه
- مصرف استامینوفن (پاراستامول) جهت کاهش علائم تب
- استراحت در خانه
- مصرف مایعات بیشتر
- تغذیه سالم و منظم
- مراقبت از علائم بیماری با پیگیری پزشکی
درمان تب مالت چقدر طول میکشد؟
در بیشتر موارد درمان تب مالت حداقل 6 هفته طول میکشد و باید تا آخرین دوز طبق نسخه داروها مصرف شوند. اگر ستون فقرات، مفصل ساکروایلیاک، قلب یا سیستم عصبی درگیر باشد معمولاً درمان به 8 تا 12 هفته یا بیشتر افزایش مییابد و ممکن است در ابتدای درمان نیاز به تزریق دارو باشد. طی دوره درمان، ویزیتهای پیگیری و تکرار آزمایشها برای ارزیابی درمان، اصلاح رژیم در صورت عارضه و تشخیص زودهنگام عود ضروری است.
بهترین دارو برای تب مالت
در بسیاری از بزرگسالان ترکیبی از داروهای تب مالت شامل داکسیسایکلین خوراکی با داروی ریفامپین انتخاب اول و موثر است. اگر بیماری شدیدتر باشد و استخوان و ستون فقرات درگیر شود، تزریق آمپول تب مالت مثل استرپتومایسین یا جنتامایسین در کنار مصرف سایر داروها در چند هفته ابتدایی مقدار میکروبها را با سرعت بیشتری، کم میکند. برخی داروها در بارداری و کودکان ممنوع است و برای این افراد باید از داروهای مختلفی استفاده کرد.
ریفامپین معمولا به صورت قرص یا کپسول تجویز میشود. برای بهبود جذب کپسول ریفامپین برای تب مالت، توصیه میشود ریفامپین را با معده خالی مصرف کنید. تهوع، استفراغ، اسهال، سردرد، خستگی و تغییر رنگ ادرار یا مدفوع از عوارض جانبی کپسول ریفامپین هستند. برای تکمیل و اثر بخش بودن سیر درمان، خودسرانه دارو را قطع نکنید در صورت بروز عوارض داروی تب مالت به پزشک خود گزارش دهید، تا شانس درمان بیشتر شود.
درمان خانگی تب مالت
درمان تب مالت در خانه ممکن نیست زیرا درمان این بیماری باید تحت نظر پزشک صورت گیرد و استفاده از هر گونه دارو گیاهی یا تکمیلی باید با اجازه و راهنمایی پزشک انجام شود. طب سنتی و داروهای گیاهی میتوانند به عنوان مکمل درمان بروسلوز استفاده شوند، اما نباید به عنوان جایگزین درمانهای مدرن و داروهای تجویز شده توسط پزشک از آنها استفاده کرد. معمولا در کنار درمان دارویی و پزشکی، درمان خانگی این بیماری میتواند روند بهبودی بیماری را تسریع کند:
- استراحت کافی و مراقبت از خود برای بهبود قدرت دفاعی
- مصرف مایعات بیشتر جهت حفظ هیدراتاسیون
- استفاده از کمپرس گرم ملایم یا فیزیوتراپی برای درد مفاصل و کمر
- خواب کافی، پرهیز از فعالیتهای شدید و استرسزا و ورزش سنگین تا زمان کنترل تب
- پاشویه و دستمال سرد روی پیشانی برای کاهش تب
- مصرف غذاهای سالم و مغذی غنی از پروتئینها، میوهها، سبزیجات و محصولات لبنی
برای تب مالت چی بخوریم؟
یک رژیم غذایی متعادل با پروتئین باکیفیت، سبزی و میوه تازه و مایعات کافی بهترین انتخاب است. عسل میتواند به عنوان خوراکی انرژیزا مفید باشد، اما درمان بیماری نیست و نباید جای آنتیبیوتیک را بگیرد. همه لبنیات باید پاستوریزه باشند و از پنیر و خامه محلی غیرپاستوریزه پرهیز شود. غذاهای بسیار چرب و سرخکردنی که تحمل گوارشی را کم میکنند بهتر است محدود شوند. غلات مانند برنج، نان، آرد گندم کامل و سایر محصولات غله حاوی کربوهیدرات پیچیده، انرژی لازم برای بهبود بدن را فراهم میکنند.
مصرف میوهها و سبزیجات تازه و غنی از ویتامین، میوههایی مانند پرتقال، لیمو، توت فرنگی، هندوانه، آناناس و سبزیجاتی مانند ریحان، نعناع و کاهو میتوانند منبع غنی از ویتامین C باشند که به افزایش سیستم ایمنی بدن کمک میکند. محصولات لبنی مانند ماست، دوغ و پنیر حاوی پروبیوتیک هستند که باعث بهبود و تقویت سیستم گوارشی میشوند.

درمان تب مالت استخوانی
درگیری استخوان و مفصل درمان طولانیتر و تهاجمیتری میطلبد. معمولا شروع درمان با تزریق آمپول تب مالت و داکسیسایکلین یا سایر داروها انجام میشود. کنترل درد، بریس حمایتی برای ستون فقرات، و فیزیوتراپی مرحلهای به حفظ عملکرد فرد کمک میکند. اگر آبسه اپیدورال، ناپایداری یا فشار عصبی مطرح باشد، مشاوره ارتوپدی یا جراحی اعصاب و گاه مداخله جراحی لازم است.
عوارض تب مالت چیست؟
اگر بروسلوز دیر تشخیص داده شود یا درمان ناقص بماند، ممکن استقسمتهای مختلفی از بدن درگیر این بیماری شوند. استخوان و مفصل بیشترین درگیری را دارند و میتوانند به محدودیت حرکتی طولانی منجر شوند. کبد و طحال ممکن است بزرگ شوند. نوروبروسلوز با سردرد، اختلال اعصاب محیطی یا مننژیت و اندوکاردیت بهعنوان خطرناکترین عارضه قلبی، هرچند نادر، ولی جدی هستند. درمان کامل و پیگیری منظم خطر این پیامدها را بهطور معناداری کاهش میدهد. برخی از عوارض تب مالت عبارت است از:
- التهاب و آسیب مفاصل
- تغییر شکل استخوان، ضعف استخوانی و حتی شکستگی استخوانها
- عوارض عصبی شامل سردرد، تشنج، ناراحتی عمومی، وزوز گوش و اختلالات روانی
- عوارض کبدی و بروز علائمی مانند تورم کبد، آزمایشهای کبدی غیرنرمال، افزایش آنزیمهای کبدی و زردی
- التهاب دریچههای قلبی، التهاب دیواره قلب و اختلالات ریتم قلبی
- عوارض تنفسی
عوارض بعد از درمان تب مالت
برخی بیماران با وجود درمان عفونت، هفتهها تا ماهها دچار خستگی، دردهای مبهم عضلانی و مفصلی یا تعریق شبانه خفیف هستند که به مرور رفع میشود. اگر درمان ناقص بوده باشد یا فرد مجدد با بیماری مواجه شود احتمال عود وجود دارد. علائمی مانند درد کمر پیشرونده، نشانههای عصبی، تنگی نفس یا تب بازگشتی باید فورا بررسی شود تا عفونت پنهان یا عارضه جدید رد شود. توانبخشی تدریجی و بازگشت به فعالیت، بهبود عملکرد را آسان میکند. برخی از عوارض بعد از درمان تب مالت به شرح زیر است:
بعد از درمان تب مالت برخی افراد همچنان با عوارض بیماری درگیر میمانند مانند:
- عوارض گوارشی نظیر تهوع، استفراغ، اسهال یا اختلالات رودهای
- واکنشهای آلرژیک مانند آنافیلاکسی (واکنش آلرژیک شدید)، خارش و تورم
- مشکلات کلیوی مانند ادرار کم، خون در ادرار، درد یا تورم در منطقه کلیه
- عوارض عمومی مانند خستگی، ضعف عمومی، سردرد، افزایش حساسیت به نور، تعریق شبانه و عدم تمرکز

آیا تب مالت کشنده است؟
اگر درمان به موقع انجام نشود، تب مالت خطرناک است اما با درمان استاندارد، معمولا مرگومیر پایین است. هرچه شروع درمان دیرتر باشد، احتمال درگیریهای استخوانی و قلبی بیشتر میشود. بنابراین در صورت مشاهده تب طولانیمدت، تعریق شبانه و سابقه مصرف لبنیات غیرپاستوریزه تعلل نکنید. تشخیص زودهنگام، رژیم آنتیبیوتیکی درست و پیگیری منظم سه ستون ایمنی هستند. التهاب لایه داخلی دهلیز قلب یکی از عوارض جانبی این بیماری است که اگر درمان نشود باعث آسیب دیدگی دریچههای قلب و مرگ فرد بعد از ابتلا به این بیماری میشود.
روش های پیشگیری از تب مالت
رعایت بهداشت مواد غذایی و پوشیدن لباس محافظ و دستکش حین کار با حیوانات بهترین راه جلوگیری از تب مالت است. برای مثال، شیر غیرپاستوریزه یا غذاهایی که با شیر خام غیرپاستوریزه پخته شدند را از رژیم غذایی خود حذف کنید. حین کار با حیوانات یا دست زدن به اندام و احشای حیوانات، حتما دستکش بپوشید. گوشت را کاملاً بپزید و از خرید محصولات محلی غیرمطمئن بپرهیزید. در سطح جامعه، واکسیناسیون و پایش دامها، دفع بهداشتی جنین سقطشده و آموزش دامداران، بار بیماری را به شکل چشمگیری کم میکند. سفر به مناطق پرخطر نیز نیازمند دقت غذایی و بهداشتی بیشتر است.
نتیجه گیری
تب مالت یک عفونت باکتریایی ناشی از باکتری بروسلا است که قابل درمان است، اما موفقیت درمان به تشخیص سریع و تکمیل یک دوره آنتیبیوتیک ترکیبی بستگی دارد. شناخت الگوی تب موجدار، تعریق شبانه، درد مفصل و کمر و یادآوری نحوه تماس با باکتری، تشخیص را سادهتر میکند و از عوارض جدی مثل اندوکاردیت پیشگیری خواهد کرد. درمان این بیماری معمولا شامل مصرف آنتیبیوتیکها برای مدت طولانی است. بهترین راه پیشگیری مصرف لبنیات پاستوریزه، پخت کامل گوشت و رعایت بهداشت است. با مراجعه بهموقع به پزشک و پایبندی به دستورهای درمانی پزشک، میتوان به زندگی عادی و بدون بیماری بازگشت.
دکترتو مراقب سلامتی شماست!


متاسفم برا کشورم چرا باید بهداشت اینقد ضعیف باشه ک دام واکسیناسیون نشه و وسط شهر باکتری تب مالت بره تو دهن ما امسال تب مالت غوغا کرده ی مریضی مسخره ک زندگی فرد مختل و نابود میکنه الان اون وزیر بهداشت کجاست ک پاسخگو باشه
سلام من خرداد ماه دچار تورم غدد لنفاوی شدم بعد از کلی آزمایش ام آر آی هزار بدبختی فهمیدم تب مالت گرفتم بعد دوماه کامل قرص و دارو خوردم آمپول هم زدم با اینکه تتیر از همون اول خیلی خیلی پایین بود ۱/۴۰ بود ولی هنوز با این همه دارو آمپول تکون نخورده ممکنه اصلا ی مریضی دیگه باشه ک آنتی بادی تب مالت و مثبت کنه
سلام
خیر
با این علایم
بیشترین چیزی که محتمل است تب مالت یا بروسلوز است
و نیاز به درمان اصولی دارد
خیر بیماری شما همون تب مالته با منفی شدن نتایج ازمایشگاهی گول نخورید و درمان رو ادامه بدید من از روز اول بیماری تیتر منفی بودم ولی تا امروز که 5 سال گذشته و 1500 تا امپول استرپتومایسین زدم هنوز کم و بیش علایم دارم و به محض کاهش دارو علایم برمیگرده
سلام یعنی تا بحال ازمایشای شما اصلا تیتر نداشته یا با دارو منفی میشه؟
آیا کمر درد زیاد هم داشتین
سلام من امروز فهمیدم تب مالت گرفتم متاسفانه یک هفته هم آی وای کردم خدا به دادم برسه ۴ماه میشود درد کمر د رد زانو وتب داشتم نمیدونستم بچه گه بودم گرفته بودم
سلام، تب مالت (بروسلوز) یک بیماری عفونی است که معمولاً از طریق تماس با حیوانات آلوده یا محصولات لبنی منتقل میشود و میتواند مزمن شود. علائم شما مثل درد کمر، درد زانو و تب طولانیمدت با عفونت مزمن هماهنگ است. این بیماری نیاز به درمان طولانیمدت با آنتیبیوتیکهای تخصصی دارد که معمولاً چند ماه ادامه پیدا میکند. حتماً هرچه سریعتر به پزشک متخصص عفونی مراجعه کنید تا دارو و دوز مناسب شروع شود، چون درمان به موقع میتواند از پیشرفت بیماری و آسیب به مفاصل و اندامها جلوگیری کند. تا مراجعه، استراحت و مصرف مایعات کافی مهم است.
متخصص عفونی
غددلنفاوی کدام ناحیه بدنتون متورم شدن؟
با سلام بنده 4ماه پیش متوجه شدم تب مالت دارم سه ماه دارو استفاده کردم و10تا امپول الان دارو استفاده نمیکنم ولی بعضا بی حالی شدید برام عارض میشه آیا از عوارض تب مالت است؟
سلام. بیحالی شدید حتی بعد از اتمام دوره درمان در تب مالت کاملاً شایع است و به دلیل ماندگاری باکتری در سلولها و ضعف سیستم ایمنی ایجاد میشود. این حالت ممکن است تا ماهها ادامه داشته باشد. استراحت کافی و تغذیه پرانرژی مانند عسل و خرما کمککننده است. اگر تب و تعریق شبانه ندارید، نگران عود نیستید. در صورت تداوم بیحالی، یکبار به متخصص عفونی مراجعه کنید تا بررسی مجدد انجام دهد.
متخصص عفونی
غددلنفاوی کدام ناحیه بدنتون متورم شدن؟ میشه جواب بدین
غده کدام قسمت بدنت ورم کرده بود چطوری مشخص شد ،اخه منم غده زیر بغلم وارنجم ورم کرده ازمایش دادم گفتن تب مالت نیست ،میگن منفی
سلام خواهشا جواب بدین ،غده کجای بدنت ورم کرده چطور فهمیدی تب ماات داری ،منم غده زی بغلم وارنجم ورم کرده ومچ پاهام درد میکنه رفتم ازمایش دادم گفتن تب مالت نداری
باسلام و خسته نباشید
14 روز پیش تب کردم و ورم بیضه چپ همراه با درد شدید که چند شب تا صبح میرفتم اورژانس مورفین میزدن واسه دردم. 4 تا دکتر اورولوژی رفتم 3 تا سونوگرافی دادم یک سونو رنگی هم دادم با کلی آزمایش دیگه. دکتر آخر گفت بیضه چرخش پیدا کرده باید عمل بشی.
روز آخر به سفارش یک دکتر عمومی آزمایش تب مالت دادم بعد مشخص شد که تب مالت من مثبت هست. واقعا متاسفم 4 تا دکتر متخصص یکی شون به ذهنش نرسید که شاید تب مالت باشه.
سلام
بله دقیقا علایم بروسلوز دارید
و کاملا مشخص است
امیدوارم درمان را با موفقیت کامل کنید
سلام والا نمیدونم اینجا چجوری تخصص گرفتن، چند وقته کمر درد و پا درد شدید گرفتم، خصوصا وقت استراحت بجز درد پاهام حرارت داشتن…. رفتم متخصص روماتولوژی کلی ازمایش و هزینه گفت چیزیت نیست سالمی، بعد رفتم پزشک عمومی روستا گفت تب مالت، واسم آزمایش نوشت مثبت شد، از امروز هم دارو استفاده میکنم
فقط با مصرف دارو تکرار ادرار گرفتم
سلام
بله این علایم از مشخصات تیپیک بروسلوز است
تکرار ادارار هم بخاطر بیماری و هم داروهای مصرفی است
و نشانه بدی نیست
با ارزوی بهترین ها
سلام خسته نباشید من ۴سال تب مالت توبدنم هسته قرص خوردم دارو هم میخورم خوب نشدم الان یک دوسالی هسته دیگه دارو مصرف نمی کنم رفتم ازمایش دادم میگه تب مالت خواستم یک راهنمایی بکنی ممنون میشم
سلام، تب مالت یا بروسلوز یک بیماری عفونی است که معمولاً با مصرف داروهای خاص درمان میشود. اگر علائم بیماری همچنان ادامه دارد و شما دارو مصرف نکردید، ممکن است نیاز به درمان دوباره با آنتیبیوتیکهای خاص و به مدت طولانیتری داشته باشید. پیشنهاد میشود که دوباره به پزشک مراجعه کنید تا درمان مناسبتری برای شما تجویز شود و وضعیت شما بررسی شود. تا زمان درمان کامل، رعایت دستورات پزشک و پیگیری مستمر اهمیت زیادی دارد.
متخصص عفونی
سلام.وقت بخیر
ببخشید تب مالت چقد طول میکشه تا خوب بشه و عفونت لعنتی از بین بره؟؟
پدر من تب مالت داره و آزمایشی که دادن میزان شاخص تب مالت را ۱۲۸۰ تا گزارش دادن؛ حالا میخواستم بدونم که چقد زمان میبره.
سلام بر شما
بهبود تب مالت در افراد مختلف میتونه متفاوت باشه و معمولاً چند هفته تا چند ماه طول بکشه، پس بهتره روند درمان و آزمایشهای پدرتون دقیقاً زیر نظر متخصص عفونی پیگیری بشه.
بهترین دکتر عفونی ایران
دقیقا مثل من
سلام دقیقا منم بیضه سمت چپم ورم کرد و با اولین آزمایش خون دکتر فوق تخصص اورولوژی گفتن که تب مالت داری و منو معرفی کرد پیش یه متخصص عفونت های داخلی
دوستان تب مالت یه دوره درمان داره که حتما باید زیر نظر دکتر متخصص عفونت های داخلی انجام بشه که باید بستری بشی و ۱۰ روز طول میکشه
من توی بیمارستان روزانه ۳تا آمپول جنتامایسین ۵۰۰ توی نصف سرم بهم تزریق میشد و تا ۳ ماه و شاید بیشتر باید قرص ریفامپین و داکسی سایکلین مصرف کنید
حتما زیر نظر متخصص یا فوق تخصص باشه
چون این آمپولا قوی هستن و ممکنه روی کلیه تاثیر بزارن و مرتب ازتون آزمایش کلیه هم میگیرن
اینم بگم که درطول درمان ممکنه جواب آزمایشتون منفی بشه که بهش توجه نکنید و درمان رو ادامه بدید خود دکتر هم همینو میگه
سلام. حسین عزیز از اینکه تجربه درمان کامل را به اشتراک گذاشتید ممنونم. تب مالت دقیقا به همین صورت با ترکیب آمپول جنتامایسین به مدت ۱۰ تا ۱۴ روز به همراه ۳ تا ۶ ماه مصرف ریفامپین و داکسی سایکلین زیر نظر بهترین دکتر عفونی ایران درمان میشود و قطع و حتی ادامهی خودسرانه دارو باعث مشکل در درمان بیماری میشود. برای ارتباط گرفتن با پزشکان در سراسر ایران اپلیکیشن دکترتو را دانلود کنید.
سلام ببخشید سوالی داشتم ..من درد استخوان لگن و کمردرد و کلا درد مفاصل داشتم دکتر ارتوپد کلی آزمایش و چکاب نوشتن و مشخص شد رماتیسم نداشتم اما گفتن تب مالت خیلی ضعیف در آزمایش نشون داده شده. دوباره برام آزمایش نوشتن
یعنی ممکنه تب مالت باشه ؟؟؟
سلام
بله احتمال بروسلوز یا تب مالت وجود دارد
و بهتر است در اوولین فرصت درمان را پیگیری کنید
متخصص عفونی
تب مالت بیماری کثیفیه که درمان نداره .تنها علاجش استراحت مطلق دوری از لبنیات وگرد خاک .سنگینی بلند نکنین .میوه زیاد بخورین .مخصوصا انار که خوب جواب میده
تب مالت بیماری کثیفیه که درمان نداره .تنها علاجش استراحت مطلق دوری از لبنیات وگرد خاک .سنگینی بلند نکنین .میوه زیاد بخورین .مخصوصا انار که خوب جواب میده
مهران عزیز
ممنونم
تب مالت بیماری قابل درمان است و برخلاف باور رایج، با داروهای مناسب میتوان آن را کاملاً کنترل و حتی ریشهکن کرد. رعایت استراحت، دوری از منابع آلوده مثل شیر غیرپاستوریزه و گوشت نپخته و مصرف میوهها مفید است، اما اصلیترین درمان، استفاده منظم از آنتیبیوتیک تحت نظر پزشک متخصص است و تنها با رژیم غذایی و استراحت بهبود کامل حاصل نمیشود.
آیا درد در ناحیه کمر و مفاصل پاها میتونه ناشی از تب مالت باشه ؟ اگ راهنمایی کنید ممنون میشم
سلام برهمه دوستان واقا ابی پدر من هم دچار تب مالت شده همین الان کنارم نشسته وکمردرد گرفت وبیضه چپ عفونت کرده بود وورم داشت به اندازه یک نارگیل شده بود که عفونتشو خارج کردیم وبعد مجدداً آنتیبیوتیک مصرف کردوالان زانودرد شدید داره وورم زانو وداغی پا ودرد مفاصل این نشانه تب مالت بود که باکلی آزمایش فهمیدیم مشکل کجاست .واینم بگم پدرم هم با دام در ارتباط داشت الآنم دارم پاشور ش میکنم خدایا شکر خوبه وبرای همه آرزوی سلامتی دارم
آیا کمر درد و درد مفاصل به تنهایی میتونه علائم تب مالت باشه . اگ راهنمایی کنید ممنون میشم
سلام
ممکن است
مخصوصا اگر همراه باشد
البته از نظر روماتیسم هم باید چکاپ شوید
برای اطمینان باید از ازمایش های تخصصی تب مالت استفاده کنید
آزمایش رایت برای تشخیص تب مالت (Wright test,Wright Agglutination, TAT, SAT) با انجام آزمایش رایت (Wright) آنتی بادی های IgM، IgA و IgG بررسی می شوند که در انتهای هفته ی دوم مرحله ی حاد بیماری در سرم ظاهر می شوند و بین هفته ی سوم تا ششم تیتر آن به حداکثر خواهد رسید.
متخصص عفونی
سلام از ۲۷ اسفند تا الان ۲۰ فروردین ۱۴۰۴ آنتی بیوتیک تجویز پزشک معالجم ولی تعریق زیاد شبانه درد مفصل ران آیا نیاز به بستری شدن در بیمارستان هست ؟لطفا راهنمایی بفرمایید سپاس 🙏
سلام
بله
تب مالت (بروسلوز) ممکن است علائم طولانیمدت و مشکلاتی مانند تب شبانه، تعریق زیاد و درد مفاصل ایجاد کند. اگر علیرغم مصرف آنتیبیوتیک، علائم شما بهبود نیافته و درد شدید مفاصل، تب بالا یا دیگر علائم نگرانکننده دارید، ممکن است نیاز به بستری شدن برای درمان بیشتر و پیگیری دقیقتری داشته باشید. توصیه میشود که سریعاً با پزشک خود مشورت کنید یا در صورت لزوم به بیمارستان مراجعه نمایید.
سلام من خودم تب مالت دارم بلی میشه
متأسفانه خیلی از دکترها تشخیص درست نمیدهند و اسم خودشون را هم گذاشتند فوق تخصص اما سواد پزشکی ندارن
سلام
چه علایمی داشتیدو به چه متخصصی مراجعه کردید؟
با سلام حدود سه ماهه که تب مالت گرفتم بخاطر مصرف داروی داکسی و ریفامپین معده درد شدید وترشح اسید معده داشتم به طور کامل نتونستم دارو ها رو کامل مصرف کنم ۱۹ تا امپول جنتاماسین مصرف کردم یک ماه حالم خوب بود اما ازمایشم تغییری نداشت دارو ها رو قطع کردم اما الان دوباره درد های من برگشته من با توجه وضعیت معده ام چه داروهای مصرف کنم
سلام
برای کمک به بهبود وضعیت معدهتان، پیشنهاد میشود که یک رژیم غذایی سبک و کمچرب را دنبال کنید و از مصرف غذاهای تند و اسیدی پرهیز کنید. همچنین، نوشیدن آب کافی برای هیدراته نگه داشتن بدن، خواب کافی و منظم برای تقویت سیستم ایمنی، و کاهش استرس با استفاده از تکنیکهای آرامسازی مانند تنفس عمیق و یوگا میتواند به کاهش علائم کمک کند. در صورت تایید پزشک، مصرف داروهای ضد اسید مانند امپرازول یا رانیتیدین و همچنین مصرف پروبیوتیکها نیز میتواند مفید باشد. این اقدامات میتوانند به کنترل وضعیت شما کمک کنند، اما مشاوره با پزشک همچنان ضروری است.
سلام شما از چی گرفتی عدد ازمایشت چنده؟
علاعمات چی هست؟
یکم توضیح میدی
تداوی قطعی بورسلوز چیست
سلام
مهمترین درمان
مصرف دقیق و اصولی آنتیبیوتیک است
انتی بیوتیک باید با تجویز پزشک مصرف شود
و ممکن است زمانبر باشد
متخصص عفونی
تو این مملکت چیزی به نام شیر پاستوریزه نداریم. این همه بیماری زیاد شده و اغلب هم شیرپاستوریزه مصرف کرده بودن.
تو این مملکت چیزی به نام شیر پاستوریزه نداریم. این همه بیماری زیاد شده و اغلب هم شیرپاستوریزه مصرف کرده بودن.
سلام من تب مالت گرفتم یه مدتیه دارو مصرف میکنم دهانم خیلی تلخه از چیه میشه توضیح بدهید؟؟
سلام و احترام
یکی از دلایل شایع، تأثیر مستقیم برخی داروها بر حس چشایی یا ایجاد خشکی دهان است که خود منجر به تلخی میشود. همچنین، خود عفونت باکتریایی تب مالت نیز میتواند بر سیستم بدن و تعادل شیمیایی دهان اثر بگذارد. نوشیدن آب فراوان، رعایت بهداشت دهان و دندان و مشورت با پزشک معالج برای بررسی تداخلات دارویی یا تنظیم دوز داروها میتواند کمککننده باشد.
من۴بارآزمایشکاملدادمدکترفوقتخصصگفتسرطانخونداریردمکردنطهرانی۵۰میلیونیآبپامخوردتادیگهمفصلامفلجکرد
تایکیازبستگانخودمگفتبروآزمایشتبمالتبدهآزمایشدادامجوابشاومده ۱۱۴۰درجهگرفتم